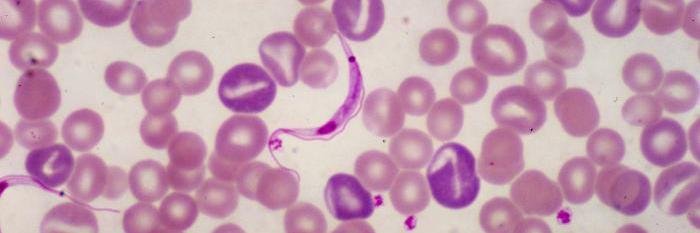
ASTMHTrainees banner

ASTMHTrainees retweetledi

After a decade of visiting the city on tour, the performer @dessadarling finally got to experience it as a tourist. nyti.ms/2mSnRSk
English
ASTMHTrainees
278 posts

@ASTMHTrainees
A group of clinical students and graduate level trainees seeking to become the new leaders of tomorrow in the field of tropical medicine.



















